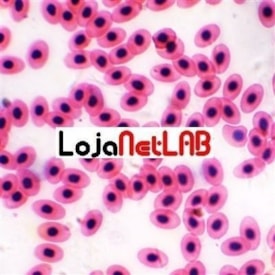
Product image

Olá seja bem-vindo, visitante

R$ 93,72 À vista com desconto no boleto

ou 10x de R$ 121,91 no cartão de crédito
ou 10x de R$ 85,27 no cartão de crédito

ou 8x de R$ 54,55 no cartão de crédito

ou 10x de R$ 148,75 no cartão de crédito

ou 10x de R$ 81,89 no cartão de crédito

ou 10x de R$ 131,37 no cartão de crédito

ou 10x de R$ 73,95 no cartão de crédito

ou 10x de R$ 111,92 no cartão de crédito

ou 9x de R$ 53,52 no cartão de crédito

ou 10x de R$ 164,16 no cartão de crédito

ou 10x de R$ 189,55 no cartão de crédito

ou 10x de R$ 156,62 no cartão de crédito
Explore o fascinante mundo da microscopia com nossa seleção de lâminas preparadas de alta qualidade. Perfeitas para estudantes, educadores e entusiastas, nossas lâminas oferecem uma janela nítida para estruturas biológicas e materiais diversos, prontas para serem observadas sob o microscópio.
As lâminas preparadas são ferramentas indispensáveis para o estudo e a pesquisa em diversas áreas. Elas eliminam a necessidade de coletar, fixar e colorir amostras, permitindo que você comece a observar imediatamente.
Nossas lâminas são cuidadosamente selecionadas para garantir a clareza e a integridade das amostras, proporcionando uma experiência de observação excepcional.
A escolha da lâmina preparada ideal depende do seu objetivo de estudo ou pesquisa. Considere os seguintes pontos ao fazer sua seleção:
Defina qual campo você deseja explorar. Temos conjuntos e lâminas individuais focadas em botânica, zoologia, anatomia, microbiologia, etc. Kits iniciantes geralmente cobrem uma gama variada para introdução.
Procure por lâminas que especifiquem o tipo de corte (transversal, longitudinal), a coloração utilizada (Hematoxilina-Eosina, Azul de Metileno, etc.) e se a amostra está bem distribuída e fixada no centro da lâmina.
Lâminas de qualidade vêm bem embaladas para evitar danos e são seladas para garantir a longevidade da amostra. Verifique se a lâmina e a lamínula estão limpas e sem bolhas de ar.
Algumas lâminas são preparadas para mostrar estruturas gerais, enquanto outras se concentram em detalhes finos de células ou tecidos específicos. Escolha de acordo com a profundidade do seu estudo.
Tem dúvidas sobre lâminas preparadas? Veja as respostas para as perguntas mais comuns:
A lâmina virgem é apenas um vidro retangular liso usado para montar suas próprias amostras. A lâmina preparada já contém uma amostra biológica ou material montado permanentemente sob uma lamínula, fixada e, geralmente, corada, pronta para observação imediata.
Sim, manuseie-as pelas bordas para evitar impressões digitais na área de observação. Guarde-as em caixas apropriadas, longe da luz direta e umidade excessiva para preservar a amostra.
Nossas lâminas preparadas são compatíveis com a maioria dos microscópios ópticos (biológicos), tanto modelos didáticos quanto modelos mais avançados. A ampliação necessária dependerá do detalhe que você deseja observar na amostra.
Apenas a superfície externa do vidro (lâmina e lamínula) pode ser limpa cuidadosamente com um pano macio e seco para remover poeira ou impressões digitais. Nunca tente remover a lamínula ou tocar na amostra interna.
A arte de preparar lâminas para microscopia é uma técnica que evoluiu ao longo de uma década, desde os primeiros microscopistas que montavam amostras temporárias. A fixação e coloração de tecidos, por exemplo, são processos que demandam precisão para preservar a morfologia celular e realçar estruturas específicas.
Nossa coleção inclui exemplos clássicos e modernos, abrangendo desde cortes finíssimos de caules de plantas até complexas estruturas de órgãos animais coradas com técnicas que facilitam a identificação de diferentes tipos celulares. Isso garante que você tenha acesso a materiais didáticos e de pesquisa da mais alta qualidade.
SIGA-NOS
@lojanetlab